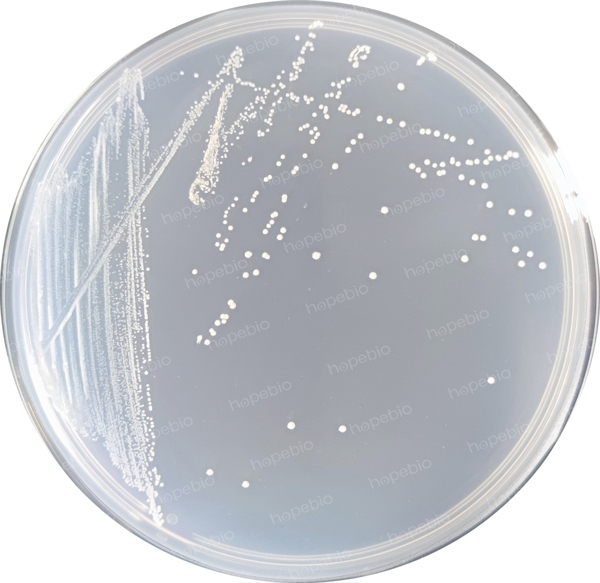

海博微信公众号
海博微信公众号
 海博天猫旗舰店
海博天猫旗舰店


 海博微信公众号
海博微信公众号
 海博天猫旗舰店
海博天猫旗舰店




一、产品介绍
产品涉及标准:《GB 5009.270-2023食品安全国家标准食品中肌醇的测定》
肌醇是酿酒酵母菌生长所必需的营养素,在一定条件下,酿酒酵母菌的生长与肌醇含量呈对应关系,以标准工作曲线为参照,根据待测液吸光度值,即可计算出待测试样中肌醇的含量。麦芽浸粉琼脂培养基在肌醇的测定中作为酿酒酵母的菌种复苏培养基使用。
用途:用于霉菌和酵母菌的分离、培养和计数。
原理:蛋白胨可提供氮源和生长因子;麦芽糖为可发酵糖类,可提供碳源;糊精为大分子糖类分解过程中的中间产物,可作为增稠剂和稳定剂;丙三醇为保护剂并可提供部分碳源;琼脂为培养基的凝固剂。
二、培养基配方(g/L)
|
蛋白胨 |
0.78 |
|
麦芽糖 |
12.75 |
|
糊精 |
2.75 |
|
丙三醇 |
2.35 |
|
琼脂 |
15.0 |
|
pH值4.7±0.2(25℃) |
|
三、试验方法
1、称取本品33.6g,加热煮沸溶解于1000mL纯化水中,混合均匀后分装三角瓶,121℃高压灭菌15分钟备用。
2、制备质控菌液接种于培养基上。
3、放置于30℃需氧培养24h-48h,观察试验结果。
四、质控结果
接种以下质控菌株,放置于30℃需氧培养24h-48h。结果如图1。
|
质控菌株 |
菌株编号 |
生长情况 |
其他特征 |
|
卡尔斯伯酵母 |
ATCC 9080 |
+++ |
生长良好 |
图1 麦芽浸粉琼脂培养基微生物质控结果
五、注意事项
培养基中含糊精,灭菌冷却后培养基稍浑浊,可能出现少量沉淀。
相关产品:
注:本文属海博生物原创,未经允许不得转载。
上一篇:DTM培养基的原理和使用方法



